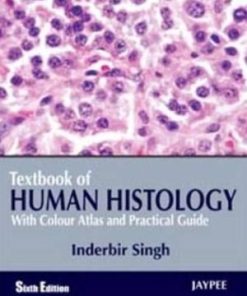
Textbook of Human Histology  With Colour Atlas & Practical Guide 6th Edition

Shop
Showing 6310–6318 of 26071 results
Filter by price
Product categories
- Aerospace Books (225)
- Biomechanics Books (49)
- Biometrics Books (15)
- Biophysics Books (32)
- Biopolymer Books (67)
- Biostatistics Books (61)
- Biotechnology Books (373)
- Cellular and Molecular Biology Books (204)
- Clinical Science (6614)
- Hydrology and Limnology Books (102)
- Hygiene and Health Books (758)
- Immunology Books (238)
- Infectious Disease Books (70)
- Internal Medicine Books (130)
- Laboratory Sciences Books (112)
- Marine Biology and Oceanography Books (99)
- Medical Documents books (9)
- Medical Education Books (544)
- Medical Informatics Books (39)
- Metabolics Books (19)
- MRCOG Books (39)
- Nuclear Medicine books (29)
- Nutrition Books (123)
- Oncology Books (269)
- Others Health Sciences and Medicine Books (521)
- Others Life Sciences and Biology Books (285)
- Oxford Books (37)
- Paleontology Books (16)
- Parasitology Books (17)
- Parkinson Books (4)
- Plant Biology Books (109)
- Proteomics Books (19)
- Scrub (35)
- Soil Science Books (40)
- Sports Medicine Books (188)
- Stem Cells Books (46)
- Telemedicine and Health Books (27)
- Toxicology Books (68)
- Traditional Medicine Books (78)
- Tropical Medicine Books (3)
- Virology Books (43)
Showing 21031–21060 of 26071 results
-

Textbook of Gastrointestinal Oncology
د.إ1,471.00 Quick View Compare -

Textbook of General Anatomy 2nd Edition
Call for Price Quick View Compare -
Sale!

Textbook of Global Health
د.إ823.00Original price was: د.إ823.00.د.إ80.00Current price is: د.إ80.00. Quick View Compare -

Textbook of Gynecologic Robotic Surgery
د.إ869.00 Quick View Compare -

Textbook of Gynecology
Call for Price Quick View Compare -

Textbook of Hemophilia 3rd Edition
Call for Price Quick View Compare -

Textbook of Hepato Gastroenterology
Call for Price Quick View Compare -

Textbook of Histology
د.إ403.00 Quick View Compare -

Textbook of Histology
د.إ403.00 Quick View Compare -

Textbook of histology 4th Ed
Call for Price Quick View Compare -

Textbook of Histology 4th Edition
Call for Price Quick View Compare -

Textbook of Histology 5th Edition
Call for Price Quick View Compare -

Textbook of Histology 5th Edition
Call for Price Quick View Compare -
Textbook of Human Histology With Colour Atlas & Practical Guide 6th Edition
Call for Price Quick View Compare -

Textbook of Human Nutrition 2nd Edition
Call for Price Quick View Compare -

Textbook of Immunology 2nd Ed
Call for Price Quick View Compare -

Textbook of Immunology 2nd Edition
Call for Price Quick View Compare -

Textbook of Immunopsychiatry
د.إ284.00 Quick View Compare -

Textbook of Inorganic Pharmaceutical and Medicinal Chemistry 11th Edition
Call for Price Quick View Compare -

Textbook of Interventional Cardiology 6th Edition
Call for Price Quick View Compare -

Textbook of Interventional Cardiology 8th Ed
Call for Price Quick View Compare -

Textbook of Interventional Cardiovascular Pharmacology
Call for Price Quick View Compare -

Textbook of Ion Channels Volume I
د.إ603.00 Quick View Compare -

Textbook of Ion Channels Volume III
د.إ521.00 Quick View Compare -

Textbook of Lasers in Dermatology
Call for Price Quick View Compare -

Textbook of Lasers in Dermatology
Call for Price Quick View Compare -

Textbook of Liver Transplantation
د.إ372.00 Quick View Compare -

Textbook of Male Genitourethral Reconstruction
د.إ1,203.00 Quick View Compare -
Sale!

Textbook of Medical Biochemistry 8th Ed by Chatterjea
د.إ456.00Original price was: د.إ456.00.د.إ200.00Current price is: د.إ200.00. Quick View Compare -

Textbook of Medical Physiology 2nd Edition
د.إ7,319.00 Quick View Compare
Recently Viewed Products
No recently viewed products to display

